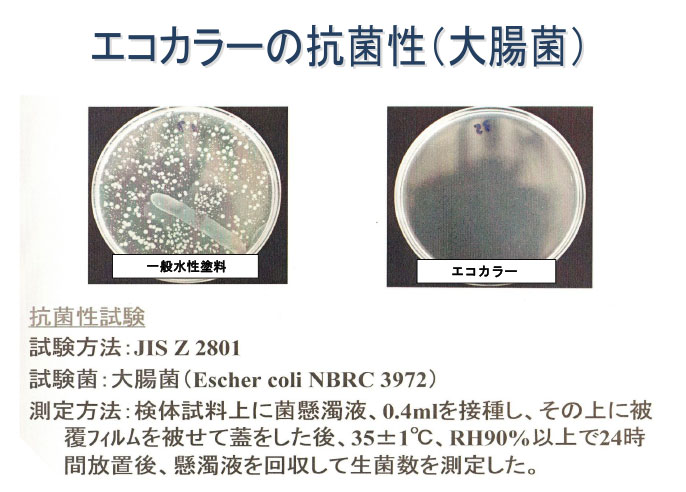
エコカラーの抗菌性8大腸菌）

- トップページ
- クロスメイクとは?
リフォーム業界に革命を起こした新技術「クロスメイク」
~ レイちゃんとライくんのクロスメイク ~

クロスメイクは、汚れた壁紙を張替えずに、上からオリジナル染色剤を塗布します。
壁紙の凹凸模様は残し汚れは真っ白に、新品同様に仕上がります。エコカラーは下地に染み込む事は無いので、ボードに張り付いて剥がせなくなる事は有りません。
施工の際に、穴や傷は再生してからクロスメイクを施しますのでまるで張替えた様な仕上りです。施工中は大きな音や、嫌な臭いが有りません。抗菌・脱臭・消臭効果・防カビ効果あり、揮発性有毒物質ホルムアルデヒド等のVOCを含んでおりませんので、ぜんそくやアレルギーの方のいるお宅、病院、店舗、ホテル等に最適な安全・安心施工です。

基本色はホワイトですが、グリーン、ブルー、グレー、ピンク、クリーム、イエロー(下記サンプル参考)に関しまして別途料金が発生しますが、色の変更可能です。
エコカラーの特徴